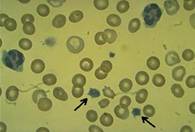
Síndrome de Bernard-Soulier de plaquetas gigantes: Trastorno familiar de la coagulación que se caracteriza por tiempo de sangrado prolongado, plaquetas inusualmente grandes y escasas y un consumo de protrombina alterado.

ACTUALIZADO JUNIO 2022
¿QUÉ ES LA TROMBOCITOPENIA?
Es un trastorno cuya característica es la escasez de plaquetas en la sangre. La trombocitopenia es decir un recuento plaquetario de menos de 150.000 plaquetas por centímetro cúbico de sangre tanto en los recién nacidos a término como en los prematuros.
Las plaquetas o trombocitos: son pequeñas células de la sangre que ayudan a la sangre a coagularse y se adhieren a los vasos sanguíneos que se hayan dañado (por heridas o por traumatismos), para detener el sangrado.

- Se forman en la médula ósea a partir de los megacariocitos y de ahí pasan a la sangre circulante.
- Solamente un pequeño porcentaje de plaquetas se consume en los procesos de coagulación, por lo que la mayoría de las plaquetas están circulando hasta que envejecen y son eliminadas.
¿QUÉ ES LA PÚRPURA?
La fundamental manifestación clínica de cualquier trastorno de plaquetas es la “púrpura” o presencia de parches y manchas de color oscuro en la piel, órganos y en las membranas mucosas, incluyendo el revestimiento de la boca.
Cuando las manchas de púrpura son muy pequeñas y como puntitos (de color rojo vinoso), se las denomina petequias y, cuando son grandes, equimosis o moretones.
¿POR QUÉ LA TROMBOCITOPENIA ES UNA PREOCUPACIÓN?
Si no existe la cantidad suficiente de plaquetas, puede producirse sangrado en los tejidos y a menudo moretones constantes en la piel.
Debido al sangrado, los glóbulos rojos se destruyen y se produce la bilirrubina, que se acumula en la sangre y provoca la ictericia (color amarillento de la piel).
El sangrado excesivo, denominado hemorragia, puede resultar peligroso y afectar tanto al cerebro como a otros aparatos y sistemas del cuerpo.
CAUSAS
Existen un gran número de factores que pueden causar la trombocitopenia o cuenta baja de plaquetas.
Este problema puede ser heredado (pasa de padres a hijos) y puede desarrollarse durante el embarazo, en las primeras 72 horas de nacido, después de las primeras 72 horas de nacido o más tarde durante la vida en cualquier edad. Algunas veces no se sabe la causa.
TROMBOCITOPENIA ADQUIRIDA
En general, la trombocitopenia adquirida está relacionada con el padecimiento que la causa y se resolverá una vez que se dé el tratamiento.
Causas de la Trombocitopenia adquirida
- Problemas en el sistema inmunológico del bebé: Se cree que problemas en el sistema inmune del bebé pueden causar la Trombocitopenia. El sistema inmune es la parte del cuerpo que lucha contra las infecciones.
- Aloinmune: También puede desarrollarse cuando el sistema inmune de la mama produce anticuerpos contra las plaquetas del bebé y se denomina Trombocitopenia aloinmune neonatal (TAIN). Los síntomas son: petequia generalizada, rash o púrpura.
- Puede nacer así o desarrollarse a los dos o tres días de nacido. Una complicación grave es el sangrado intracraneal que puede suceder durante el embarazo.
- Puede verse afectado desde el primer bebé (este no es el caso cuando se trata de incompatibilidad con el Rh).
- El diagnóstico requiere la demostración de la incompatibilidad plaquetaria entre la madre y el bebé y la ausencia de antígenos (anticuerpos) en el suero de la madre, los cuales están presentes en el bebé.
- Infecciones: Infecciones bacterianas severas, enterocolitis necrotizante (inflamación de los intestinos) o infecciones virales. El 80% de los bebés con una infección comprobada, tienen las plaquetas bajas (son trombocitopénicos).
- Transmitidas de la madre al bebé: principalmente por infecciones como: rubéola, herpes, citomegalovirus, toxoplasmosis, sífilis, etc.
- El mecanismo es generalmente una combinación de una acelerada destrucción de plaquetas con una producción disminuida.
- Inducida por algún medicamento: Como resultado de la administración de determinados medicamentos (que impiden la formación de plaquetas) ya sea a la madre durante el embarazo o al bebé.
- Se desconocen los mecanismos por los cuales los medicamentos producen trombocitopenia en la madre y en el bebé, pero pueden estar relacionados a una reacción del sistema inmunológico.
- Genética, aneuploidia (mutaciones o cambios en el número de cromosomas), que pueden dar lugar a enfermedades genéticas: trisomías 13, 18 y 21 o triploidia (este tipo de padecimientos no son heredados).
- Consumo periférico aumentado de plaquetas por diversos padecimientos: coagulación intravascular diseminada (CID, este padecimiento se ve principalmente en los prematuros), hiperesplenismo (función incrementada del bazo), etc.
- Enfermedad severa del Rh.
- Insuficiencia de la placenta.
- Leucemia neonatal (rara). Neuroblastoma congénito.
- Otros: asfixia neonatal, retardo en el crecimiento durante el embarazo por eclampsia.
Sin embargo, la causa de esta condición puede ser desconocida y ser llamada púrpura trombocitopénica idiopática o PTI. La PTI puede ocurrir en niños por lo demás sanos que repentinamente inician con signos de sangrado como moretones.
Dependiendo de la edad en la que se inicie el problema, variarán las causas.
En los recién nacidos, la supresión de la médula por infecciones, la trombocitopenia aloinmune (TAIN) y la transferencia pasiva de anticuerpos de la madre que padece Púrpura Trombocitopénica Inmune (PTI), son las causas principales de la presencia de este problema.
TROMBOCITOPENIA CONGÉNITA (PRIMARIA)
La trombocitopenia congénita se presenta generalmente durante el periodo prenatal o en el momento en que el bebé empieza a gatear o a caminar.
Los problemas más leves se hacen presentes a lo largo de la vida en los momentos de estrés hemostático: por ejemplo al principio de la menstruación, en una cirugía, durante algún trauma o incluso durante el nacimiento.
Un gran grupo de estos individuos con trombocitopenia congénita pueden no tener ningún síntoma y sólo serán diagnosticados con ligera trombocitopenia durante algún examen de rutina.
Aunque el inicio del padecimiento de este grupo de personas puede ser agudo, es importante que el médico revise los análisis previos que se haya realizado y que pregunte si existe tendencia para que se hagan moretones, si los sangrados son prolongados o hay presencia de petequias y que haga una historia familiar muy completa.
Una revisión completa de los sistemas podría revelar condiciones asociadas que le ayudarían al médico a colocar la trombocitopenia dentro de algún síndrome o le darían la explicación para cuando el padecimiento es secundario y de esto dependerá el tratamiento.
Dado que muchas de las trombocitopenias congénitas tienen cambios clásicos en la forma de las plaquetas, siempre debe hacerse un examen cuidadoso de la muestra de sangre en todos los pacientes que hayan sido diagnosticados con este padecimiento.
CLASIFICACIÓN DE LA PÚRPURA TROMBOCITOPÉNICA CONGÉNITA
Tradicionalmente, las trombocitopenias congénitas se han dividido en categorías basadas en la información que se puede obtener:
- De acuerdo al tamaño de las plaquetas
- De acuerdo a las características clínicas y la historia familiar: edad en la que se presenta, severidad, anormalidades del desarrollo asociadas a este padecimiento, etc.
- Si en la historia familiar existen casos de trombocitopenia, esto debe hacer sospechar al médico que se trata de una trombocitopenia congénita y no de una autoinmune (adquirida).
- De acuerdo a la mutación genética: en este caso los síndromes se agruparán por patrón de herencia: autosómico dominante, autosómica recesiva y ligada al cromosoma X. Esta clasificación es la que veremos a continuación.
TROMBOCITOPENIAS AUTOSÓMICAS DOMINANTES
Si una enfermedad es autosómica dominante, quiere decir que la persona sólo necesita recibir el gen anormal de uno de los padres para heredar la enfermedad.
Dentro de esta categoría están incluidos los siguientes síndromes: la anomalía de May-Hegglin (trombocitopenia familiar con inclusiones de leucocitos), el síndrome de Fetchner, el síndrome de Sebastián, el síndrome de Epstein.
La distinción clínica entre estos problemas es muy complicada y puede haber una presencia variable de problemas del riñón (nefritis) y pérdida de la audición en una misma familia o en un mismo individuo a diferentes edades. El sangrado tiende a incrementarse ligeramente en los individuos afectados.
- Etiología: se encuentra en la misma región del cromosoma 22q12-13.
- Diagnóstico: La macrotrombocitopenia se descubre generalmente al estar realizando pruebas de rutina en un individuo que no ha tenido síntomas. Por lo general, los individuos afectados con esta mutación no sufren grandes hemorragias.
- Es importante que el médico defina el diagnóstico, esto evitará tratamientos que pueden ser peligrosos y que se receten medicamentos que no se necesitan.
- La transfusión de plaquetas debe ser efectiva para cualquier sangrado causado por alguna cirugía o trauma. Es un problema que no se puede prevenir.
TROMBOCITOPENIA MEDITERRÁNEA: en el sur de Europa es relativamente común encontrar una forma ligera de trombocitopenia.
Debido a que nunca se presentó algún sangrado o moretón significativo, los afectados se descubren, generalmente, por accidente durante los exámenes de sangre rutinarios.
Al igual que en los casos anteriores, este problema está asociado con plaquetas de tamaño grande que funcionan normalmente. El grado de trombocitopenia es menos severo.
- Etiología: El análisis realizado a varias familias ha determinado la mutación genética en el brazo corto del gen 17.
- Estos datos demuestran que para varias de las familias con trombocitopenia Mediterránea, el genotipo (la herencia transmitida a través de los genes y que forman el genoma) y el fenotipo (la manifestación visible de un individuo), son equivalentes a los que llevan el síndrome de Bernard Soulier.
- Tratamiento: No es necesario ningún tratamiento.
Desorden familiar plaquetario con malignidad mieloidea asociada: en 1996 se reportó el caso de un grupo familiar grande con trombocitopenia autosómica dominante y una fuerte predisposición a malignidad en la sangre.
- Etiología: Los estudios determinaron la falla en el gen 21q22-1-22-2.
- Tratamiento: Es muy probable que los individuos afectados tendrán que recibir trasplante de médula.
Trombocitopenia autosómica dominante ligada al cromosoma 10: los afectados tienen un tipo leve de trombocitopenia, las plaquetas son normales de tamaño, forma y función.
Los síntomas de sangrado se reducen a moretones, petequias y las hemorragias se presentan únicamente en los momentos de estrés: cirugía, partos, etc.
- El gen mutado en este caso no ha sido plenamente identificado. La historia natural sugiere que las hemorragias serias son raras y que no hay tendencia a que se haga maligno por lo que es importante establecer el diagnóstico para evitar tratamientos no necesarios.
Trombocitopenia Paris-Trousseau: este tipo de trombocitopenia se ha asociado con el cromosoma 11q. Las plaquetas son más grandes de lo normal y tienen características especiales.
Esto les hace propensos a los moretones, y a sangrar abundantemente si se produce una herida, lo que supone un mayor riesgo de padecer una hemorragia interna. Incluso un sangrado de la nariz les puede causar una gran pérdida de sangre.
Este problema se manifiesta de forma doble: al nacer estos niños, los niveles de plaquetas son bajos (trombocitopenia).
Además, cuando las plaquetas se elevan hasta niveles normales, lo que generalmente ocurre durante la infancia, persiste una anomalía en la función plaquetaria.
La gravedad de esta disfunción es muy variable (desde ser escasamente perceptible hasta llegar a poner en peligro su vida), pero los niños que tienen el Síndrome de Jacobsen tendrán un elevado riesgo de hemorragias durante toda su vida.
Trombocitopenia del Síndrome Gris: El síndrome gris de la plaqueta (TSG) es un desorden congénito raro de la sangre en el cual la trombocitopenia se asocia a tamaño creciente de la plaqueta y a la disminución de la función de la plaqueta.
En este caso las plaquetas tienden a tomar un color grisáceo al teñirlas para el estudio de la sangre. No se conoce cuál es el gen afectado y se piensa que puede haber formas de herencia recesiva.
TROMBOCITOPENIAS AUTOSÓMICAS RECESIVAS
Un trastorno autosómico recesivo significa que deben estar presentes dos copias de un gen anormal (padre y madre) para que se desarrolle la enfermedad o el rasgo.
Trombocitopenia amegacariocítica congénita: En un recién nacido con trombocitopenia severa y ausencia de megacariocitos (MKS) en la médula ósea, debe sospecharse de una trombocitopenia amegacariocítica. La trombocitopenia amegacariocítica congénita (TAC) es una enfermedad de herencia autosómica recesiva.
- Diagnóstico:La trombocitopenia y la megacariocitopenia (los megacariocitos están disminuidos o ausentes) son datos que están presentes durante el primer año de vida y, en vez de mejorar, la condición empeora antes de la primera década de vida llegando a pancitopenia (deficiencia de cualquier tipo de células sanguíneas).
- Puede confundirse con otros tipos de síndromes: anemia de Fanconi, anemia aplásica y diskeratosis congénita.
- Como es un padecimiento autosómico recesivo, ambos padres son individuos sanos tienen una cuenta normal de plaquetas y funcionan correctamente por lo que se les llama “portadores”.
- Los bebés afectados son identificados a los pocos días de vida por la tendencia para presentar moretones y tener sangrados.
- Existen formas menos severas en las que el bebé tiene suficientes plaquetas como para hacer el coágulo y detener los sangrados de los vasos sanguíneos dañados.
- El diagnóstico diferencial incluye a varios trastornos genéticos: el más notable es el del hueso del radio (uno de los huesos del antebrazo) ausente y el síndrome de Wiskott-Aldrich.
- Generalmente estos se pueden distinguir de la Trombocitopenia Amegacariocítica Congénita, basándose en los cambios de los huesos de los brazos.
- En contraste con la TAC (trombocitopenia amegacariocítica), tanto la TPI (trombocitopenia idiopática) como la TAIN (trombocitopenia aloinmune neonatal), se resuelven por sí solascuando los anticuerpos son erradicados del organismo del bebé.
- Tratamiento: El tratamiento inicial de los bebés con TAC es la transfusión de plaquetas suficiente para impedir un sangrado peligroso. Sin embargo, el único tratamiento a largo plazo es el trasplante de médula que deberá hacerse en cuanto se confirme el diagnóstico y se encuentre al donante apropiado.
Trombocitopenia con radio ausente (TAR): Este síndrome es muy raro. Incluye antebrazos más cortos o ausentes debido al defecto en el desarrollo del radio (uno de los huesos del antebrazo) de ambos brazos asociado con trombocitopenia severa al nacimiento.
Los defectos óseos se ven también en otros de los huesos del brazo pero no afecta ni a las manos ni a los dedos.
Generalmente, el grado de trombocitopenia es mayor en el momento del nacimiento y seguramente se necesitará una transfusión inmediata de plaquetas. Sin embargo, la trombocitopenia se hace menos severa durante el primer año de vida y la mayoría de estos individuos no necesitarán transfusiones de plaquetas después de la infancia.
Los padres de estos bebés son completamente sanos lo que indica un patrón de herencia autosómico recesivo.
Síndrome de Bernard-Soulier de plaquetas gigantes: Trastorno familiar de la coagulación que se caracteriza por tiempo de sangrado prolongado, plaquetas inusualmente grandes y escasas y un consumo de protrombina alterado.
Problemas ligados al cromosoma X
Las enfermedades ligadas al cromosoma X pueden ser debidas a la presencia de un número anormal de copias del cromosoma X en las células (aberraciones cromosómicas de tipo numérico) o a mutaciones de genes presentes en este cromosoma.
El Síndrome de Aldrich-Wiskott y mutaciones GATA-1 forman parte de un grupo de padecimientos que se heredan en forma recesiva ligados al cromosoma X (el cromosoma del sexo) los cuales se expresan como mujeres portadoras asintomáticas y hombres portadores enfermos.

Trombocitopenia causada por una mutacion novel del gen GATA_1
El síndrome de Wiskott- Aldrich fue descrito por primera vez en 1937, afecta a los hombres casi exclusivamente e incluye trombocitopenia que puede ir desde moderada a severa, inmunodeficiencia y eczema.
Una forma más leve es la Trombocitopenia ligada al cromosoma X (TLX) en la cual la inmunodeficiencia y el eczema no son significativos. Una característica distintiva de estos padecimientos es la presencia de microtrombocitos (plaquetas pequeñas) y escasas.
- Diagnóstico:en cualquier bebé o niño que tenga trombocitopenia o inmunodeficiencia debe considerarse el diagnóstico del síndrome de Wiskott- Aldrich (SWA) y la presencia de microtrombocitos aumenta esta posibilidad.
- Los primeros signos clínicos generalmente están relacionados con episodios hemorrágicos del cordón umbilical o del tracto digestivo; el eczema, rebelde al tratamiento, también suele aparecer en forma temprana.
- Los bebés afectados con SWA generalmente son detectados antes del año de vida por la presencia de moretones continuos e infecciones recurrentes (bacteriales más que virales).
- Etiología:el gen mutado se encuentra en el brazo corto del cromosoma X.
- Tratamiento:las infecciones son la causa más común de muerte de los niños afectados con el SWA pero en las últimas décadas se ha logrado aumentar el pronóstico de vida de 5 años a 10 a 20 años o más gracias al uso de gama globulina y antibióticos de amplio espectro.
- Las hemorragias se tratan con transfusiones de plaquetas. Para el tratamiento del eczema es necesario acudir a un dermatólogo.
- Los individuos de más de 20 años de edad presentarán una incidencia cada vez mayor de enfermedades autoinmunes y linfomas.
- La única terapia curativa es el trasplante de médula que corrige tanto la trombocitopenia como la inmunodeficiencia.
Mutación GATA-1 una nueva forma de trombocitopenia ligada al cromosoma X: este problema se distingue del SAW por la presencia de plaquetas de tamaño normal y la ausencia de la inmunodeficiencia y del eczema y aparición de linfomas.
El grado de trombocitopenia es marcado pero la anemia resultante es variable. Los sangrados y moretones son severos y los estudios muestran que la función de las plaquetas también está disminuida.
- Diagnóstico:las mutaciones deben sospecharse en los niños con trombocitopenia severa, plaquetas de normales a grandes y ausencia de inmunodeficiencia y eczema.
- Tratamiento:estos individuos responden bien a las transfusiones de plaquetas las cuales se deben restringir a los momentos de hemorragia y trauma. En caso de riesgo de muerte por anemia, se puede hacer trasplante de médula como tratamiento curativo.
A pesar de que los análisis clínicos se hayan realizado cuidadosamente, hay algunos individuos que no entran en ninguna de las categorías descritas anteriormente.
Para estos casos, es necesario acudir a un médico hematólogo especializado en desordenes congénitos de plaquetas quien le realizará otros estudios para identificar la causa.
SÍNTOMAS DE LA TROMBOCITOPENIA
A continuación se enumeran los síntomas más comunes de la trombocitopenia. Sin embargo, cada bebé puede experimentarlos de una forma diferente. Los síntomas pueden incluir:
- Petequias (pequeños puntos rojos en el cuerpo)
- Púrpura (manchas rojas de moretones).
- Sangrado de las encías, nariz y boca.
- Bajo recuento de plaquetas.
- Ictericia(color amarillento de la piel).
En los casos severos donde puede haber sangrado en el cerebro y en los intestinos, los signos y síntomas pueden incluir:
- Abultamiendo de las fontanelas (mollera) en la cabeza del niño.
- Somnolencia o dificultad para despertarse.
- Vómito repetido o forzado (devolver).
- Convulsiones (ataques).
- Sangre en la orina o en las heces fecales.
Los síntomas de la trombocitopenia pueden parecerse a los de otros trastornos o problemas médicos. Siempre consulta al pediatra para obtener un diagnóstico.
DIAGNÓSTICO
Tu médico hará el diagnóstico basándose en la historia médica, el examen físico y los resultados de los estudios de laboratorio.
Una vez que se haya diagnosticado el padecimiento, el médico empezará a buscar la causa.
El médico hará primero una historia de la madre preguntando si no hay otro caso en la familia, si tomó algunos medicamentos o si has estado expuesta o has padecido alguna infección.
Y te preguntará también acerca del bebé:
- ¿Es la primera vez que tiene manchas como éstas?
- ¿Cuándo se desarrollaron?
- ¿De qué color son?
- ¿Tienen aspecto de moretones o hematomas?
- ¿Qué medicamentos está tomando?
- ¿Qué otras enfermedades ha padecido?
- ¿Qué otros síntomas se presentan?
En la exploración física el médico palpará el abdomen del bebé para ver si tiene el hígado y el bazo crecidos (hepatoesplenomegalia), si hay ictericia (piel amarilla), moretones o si existe alguna otra malformación congénita.
Verás que observa, con especial cuidado, si existe alguna anormalidad en los brazos o en los dedos o si hay alguna característica especial en las facciones que sugiera la asociación a algún síndrome.
PRUEBAS DE LABORATORIO
Además del examen físico y los antecedentes médicos completos, las pruebas de laboratorio de la sangre pueden indicar una disminución en el recuento de plaquetas, tu médico seguramente pedirá que le hagan los siguientes estudios a tu bebé:
Hematocrito completo para medir los niveles de glóbulos rojos, glóbulos blancos y plaquetas, si hay trombocitopenia, el resultado de este estudio mostrará una cuenta baja de plaquetas.
- Laminilla con sangre para checar la apariencia de las plaquetas en el microscopio.
- Otros estudios de la sangre. Si se sospecha un problema de sangrado, es probable que sea necesario realizar también otros estudios más especializados de la sangre para verificar la coagulación.
- Ultrasonido del bazo que le permitirá ver si el bazo está o no crecido.
- Puede ser necesario realizar una biopsia de médula ósea para checar que la médula está sana y produce el número adecuado de plaquetas.
TRATAMIENTO
El tratamiento específico para la trombocitopenia será determinado por el médico basándose en lo siguiente:
- La edad gestacional del bebé (¿de cuántas semanas nació?), su estado general de salud y los antecedentes médicos.
- La reacción del bebé a determinados medicamentos, procedimientos o terapias.
- Las expectativas para la evolución de la enfermedad
- Tu opinión o preferencia
El tratamiento dependerá con frecuencia de la causa de la trombocitopenia, pero es posible que se necesite una transfusión de sangre con plaquetas, administración de medicamento como antibióticos; uso de otros medicamentos que ayuden a prevenir la dificultad respiratoria y cardiaca; en algunos casos será necesaria una cirugía y tratamiento ortopédico para el problema de los huesos.
Si tu bebé tiene trombocitopenia, trata de protegerlo de los golpes y traumatismos, especialmente los de la cabeza que pudieran causar sangrado en el cerebro. Pregúntale a tu médico si necesitas restringir las actividades del bebé.
PREVENCIÓN
Que los padres que hayan tenido un hijo, o padezcan la enfermedad, acudan al Consejo Genético para determinar el riesgo de que se presente en otro hijo.
COMPLICACIONES
DERIVADAS: Hemorragia en el cerebro con convulsiones, sangre en las evacuaciones que le dan un aspecto negro a éstas, anemia que se presenta en forma rápida por el sangrado. El retraso mental no es muy frecuente, insuficiencia respiratoria y cardiaca.
ASOCIADAS: La mayoría de las formas no tienen ninguna anormalidad asociada. El Síndrome de TAR si se puede acompañar por problemas congénitos del corazón y luxación congénita de cadera.
PRONÓSTICO
El pronóstico varía según la gravedad de los síntomas y complicaciones que se presenten.
En el 50% es bueno para la vida, aunque el cuidado en los primeros meses de vida es muy problemático para los padres, sobre todo por las hemorragias y las infecciones repetidas.
El tratamiento generalmente puede controlar el sangrado. Sin embargo, los defectos congénitos de la función plaquetaria son trastornos de por vida para los cuales no hay cura.
Los individuos afectados deben tomar precauciones para evitar sangrados.
PROBABILIDAD DE QUE SE REPITA
En la Ciudad de México la Púrpura Trombocitopénica congénita se presenta en uno de cada 110 000 recién nacidos vivos.
Es más frecuente en el sexo femenino con una proporción de hombres uno, mujeres dos.
Las formas causadas por medicamentos, infecciones, etc. NO se vuelven a repetir a menos que se vuelva a estar expuesto.
Cuando se trata de formas recesivas el riesgo de que se vuelva a presentar es del 25% por cada embarazo cuando alguno de los padres es portador del gen.
REFERENCIAS
- MedlinePlus, Información de salud para usted, Temas de salud, Púrpura Trombocitopénica Inmune (PTI), https://medlineplus.gov/spanish/ency/article/000535.htm
- Geosalud, Susitio de salud en la web, Púrpura Trombocitopénica Idiopática, https://www.geosalud.com/hematologia/purpura.htm
- Mayo Clinic, Atención al paciente e información médica, Enfermedades y afecciones, Trombocitopenia inmunitaria, https://www.mayoclinic.org/es-es/diseases-conditions/idiopathic-thrombocytopenic-purpura/symptoms-causes/syc-20352325
- Stanford Children´s Health, Púrpura Trombocitopénica Inmune (idiopática) en niños, https://www.stanfordchildrens.org/es/topic/default?id=immune-thrombocytopenic-purpura-in-children-90-P05424